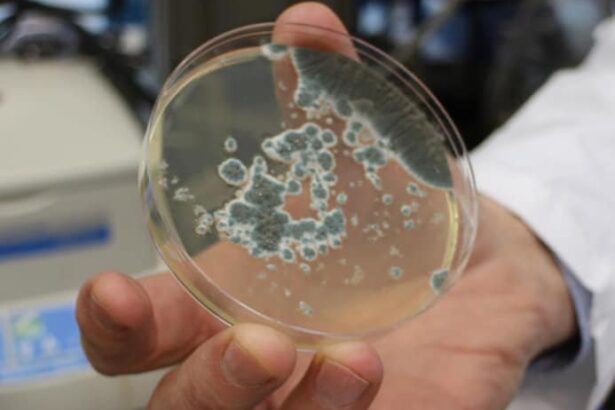

Đại học James Cook của Úc ngày 3/10 thông báo một trong những loại nấm độc nhất thế giới đã được phát hiện lần đầu tiên tại cực Bắc Úc, cách nơi sinh trưởng gốc của loài này ở miền núi Nhật Bản và Hàn Quốc hàng nghìn dặm.
Loài nấm trên có tên Poison Fire Coral (nấm độc San hô Lửa), được một nhiếp ảnh gia địa phương phát hiện ở ngoại ô Cairns và sau đó được các nhà khoa học nhận dạng.
Nhà nghiên cứu về nấm của đại học James Cook, ông Matt Barrett cho biết phát hiện trên đã mở rộng “đáng kể” khu vực mà loài nấm này có thể sinh trưởng.

Một số người tại Hàn Quốc và Nhật Bản đã thiệt mạng sau khi nhầm loại nấm màu lửa này với các loại nấm ăn được thường dùng trong y học truyền thống.
Poison Fire Coral nổi tiếng với các chất độc có thể hấp thụ qua da và gây một loạt triệu chứng nguy hiểm nếu ăn phải, như nôn, đi ngoài, sốt và liệt. Nếu không được xử lý, chất độc này có thể làm suy yếu đa cơ quan hoặc gây bại não, dẫn tới tử vong.
Nhiếp ảnh gia Ray Palmer, một người “mê nấm” đã chụp được bức ảnh Poison Fire Coral ở Cairns cho biết ông đã dành cả một thập kỷ qua để chụp ảnh về các loài nấm ở rừng mưa quanh thành phố Cairns quê hương mình.
Theo TTXVN

No comments.
You can be the first one to leave a comment.